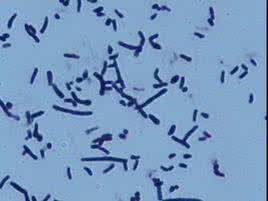
藍灰色異壁放線菌

基本信息
編號:AMS-84-19
期刊:微生物學報 24(4):295-298, 1984.
拉丁學名:Actinoalloteichus cyanogriseus sp. n. Liu Zhiheng, Zhang Yamei, and Yan Xunchu
中文菌名:藍灰色異壁放線菌 (劉志恆 張亞美 閻遜初 )
藍灰色異壁放線菌
藍灰色異壁放線菌發表文章:放線菌目中的一個新屬
作者:劉志恆 張亞美 閻遜初
作者單位:中國科學院微生物研究所細菌分類學實驗室放線菌分類組, 北京 100080
中文摘要
自我國雲南省熱帶植物園的土壤中, 分離到一株好氣中溫放線菌Y388. 該菌株氣線藍灰色, 粉狀, 形成直形或柔曲氣生孢子絲, 孢子卵圓或短桿狀,表面光滑或略粗糙. 基絲深灰至黑棕, 分隔並有斷裂和自溶. 產生淡紫色至青灰色可溶性色素. 細胞壁為II型+賴氨酸, 全細胞水解液含半乳糖. DNA中G+C 含量為69.54克分子%. 根據該菌株的形態和細胞壁化學組分與現有放線菌目中已知屬的不同, 因此成立新屬 ---異壁放線菌屬Actinoalloteichus gen.n..典型菌為蘭灰色異壁濃線菌 Actinoalloteichus cyanogriseus n. sp.. 典型菌株為Y388.
其他內容
采 集 地:西雙版納自然保護區中國科學院熱帶植物研究所院內橡膠樹下羊齒植物根際土
生態環境:熱帶濕潤季風氣候熱帶雨林
寄主:橡膠樹下羊齒植物根際土
采 集 人:劉志恆 張亞美
保存單位:中國科學院微生物研究所普通微生物保藏中心, 北京 100080
盤點質控菌株(二)
| 要搞好臨床微生物學檢驗質控,必須保存有一批標準菌株,作為對儀器、培養基、染色液、試劑和診斷血清的質控菌株,也可作為從事細菌檢驗的工作人員熟悉某些菌株的教具。 |

